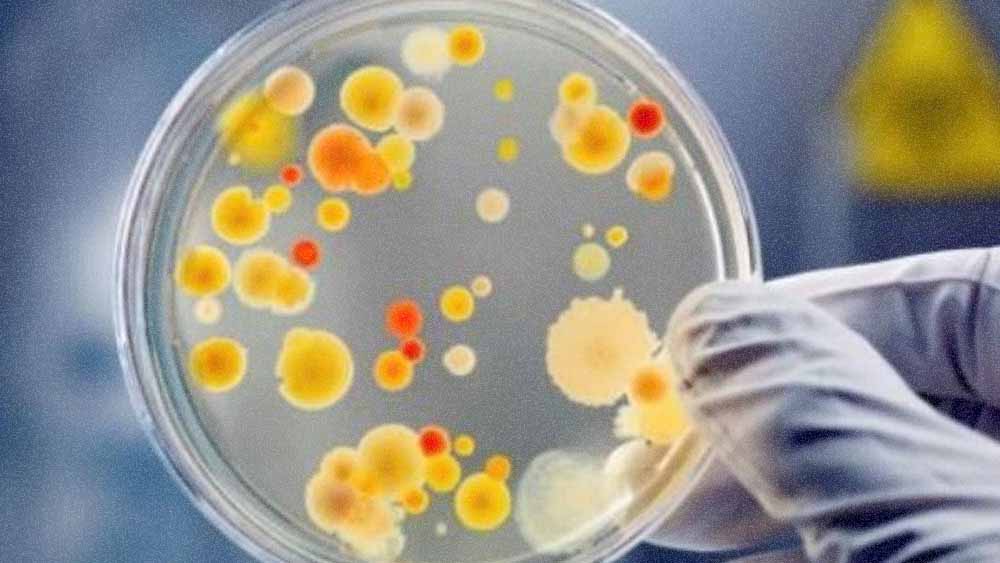
Інформує Лубенський підрозділ ДУ "«Полтавський обласний центр контролю та профілактики хвороб"

Слава Україні! Розпочалася 1224-та доба широкомасштабної збройної агресії рф проти України. Українські захисники стійко стримують натиск окупантів, завдаючи ворогу значних втрат. Загалом протягом минулої доби зафіксовано 146 боєзіткнень.
Вчора противник завдав по позиціях українських підрозділів та населених пунктах один ракетний удар, застосувавши чотири ракети, а також 51 авіаудар, скинувши 79 керованих бомб. Крім цього, здійснив 5304 обстріли, зокрема 107 – із реактивних систем залпового вогню, та залучив для ураження 3776 дронів-камікадзе.
Наші воїни завдають окупаційним військам відчутних втрат у живій силі та техніці, активно підриваючи наступальний потенціал ворога у тилу. Загалом, минулої доби втрати російських загарбників склали 970 осіб. Також українські воїни знешкодили три танки, шість бойових броньованих машин, 36 артилерійських систем, 144 безпілотні літальні апарати оперативно-тактичного рівня та 103 одиниці автомобільної техніки окупантів. Наші воїни завдають окупаційним військам відчутних втрат у живій силі та техніці, активно підриваючи наступальний потенціал ворога у тилу. Загалом, минулої доби втрати російських загарбників склали 970 осіб. Також українські воїни знешкодили три танки, шість бойових броньованих машин, 36 артилерійських систем, 144 безпілотні літальні апарати оперативно-тактичного рівня та 103 одиниці автомобільної техніки окупантів.